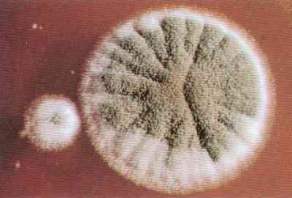

Fongs 
Pertany al regne d`éssers vius eucariotes
que comprèn organismes heteròtrofs (sense pigments assimiladors),
que viuen de forma lliure en medis humits on abunda la matèria orgànica,
o be com a simbionts, sapròfits o paràsits d'altres organismes.
Alguns fongs són unicel·lular, amb cèl·lules
de forma esfèrica o omoide, però més generalment són
pluricel·lulars, d'estructura tal·lofítica. En aquests
darrers el tal·lus està format per filaments (hifes) que
en conjunt constitueixen el miceli.
En alguns casos les hifes presenten estructura
sifonal (sense septes de separació entre les cèl·lules)
i en d'altre són septades. Es
reprodueixen tant de manera asexual (amb gran diversitat de tipus d'espores)
com com sexual. Certs fongs produeixen cossos fructífers, alguns
de mida molt gran, que són coneguts vulgarment amb el nom de bolets.
El regne dels fongs comprèn tres
divisions:
els mixomíceps, els monadomicets
i els amonadomicets. La divisió, dels mixomicets és la més
atípica, i la seva inclusió en el regne resulta discutible.
Els monadomicets són microscòpics, no presenten miceli o
bé el tenen sense tabicar i posseeixen elements mòbils amb
un o dos flagels; comprèn les classes arquimicets i ficomicets.
En la divisió dels amonadomicets es reuneixen els fongs que presenten
hifes tabicades i comprèn les classes ascomicets, fongs imperfectes
i basidiomicets. Alguns fongs són d'un gran interès per a
l'home, per tal com s'usen en processos industrials des de
fa molt de temps (fermentació de mostos, indústries làcties,
planificació etc.)
 |